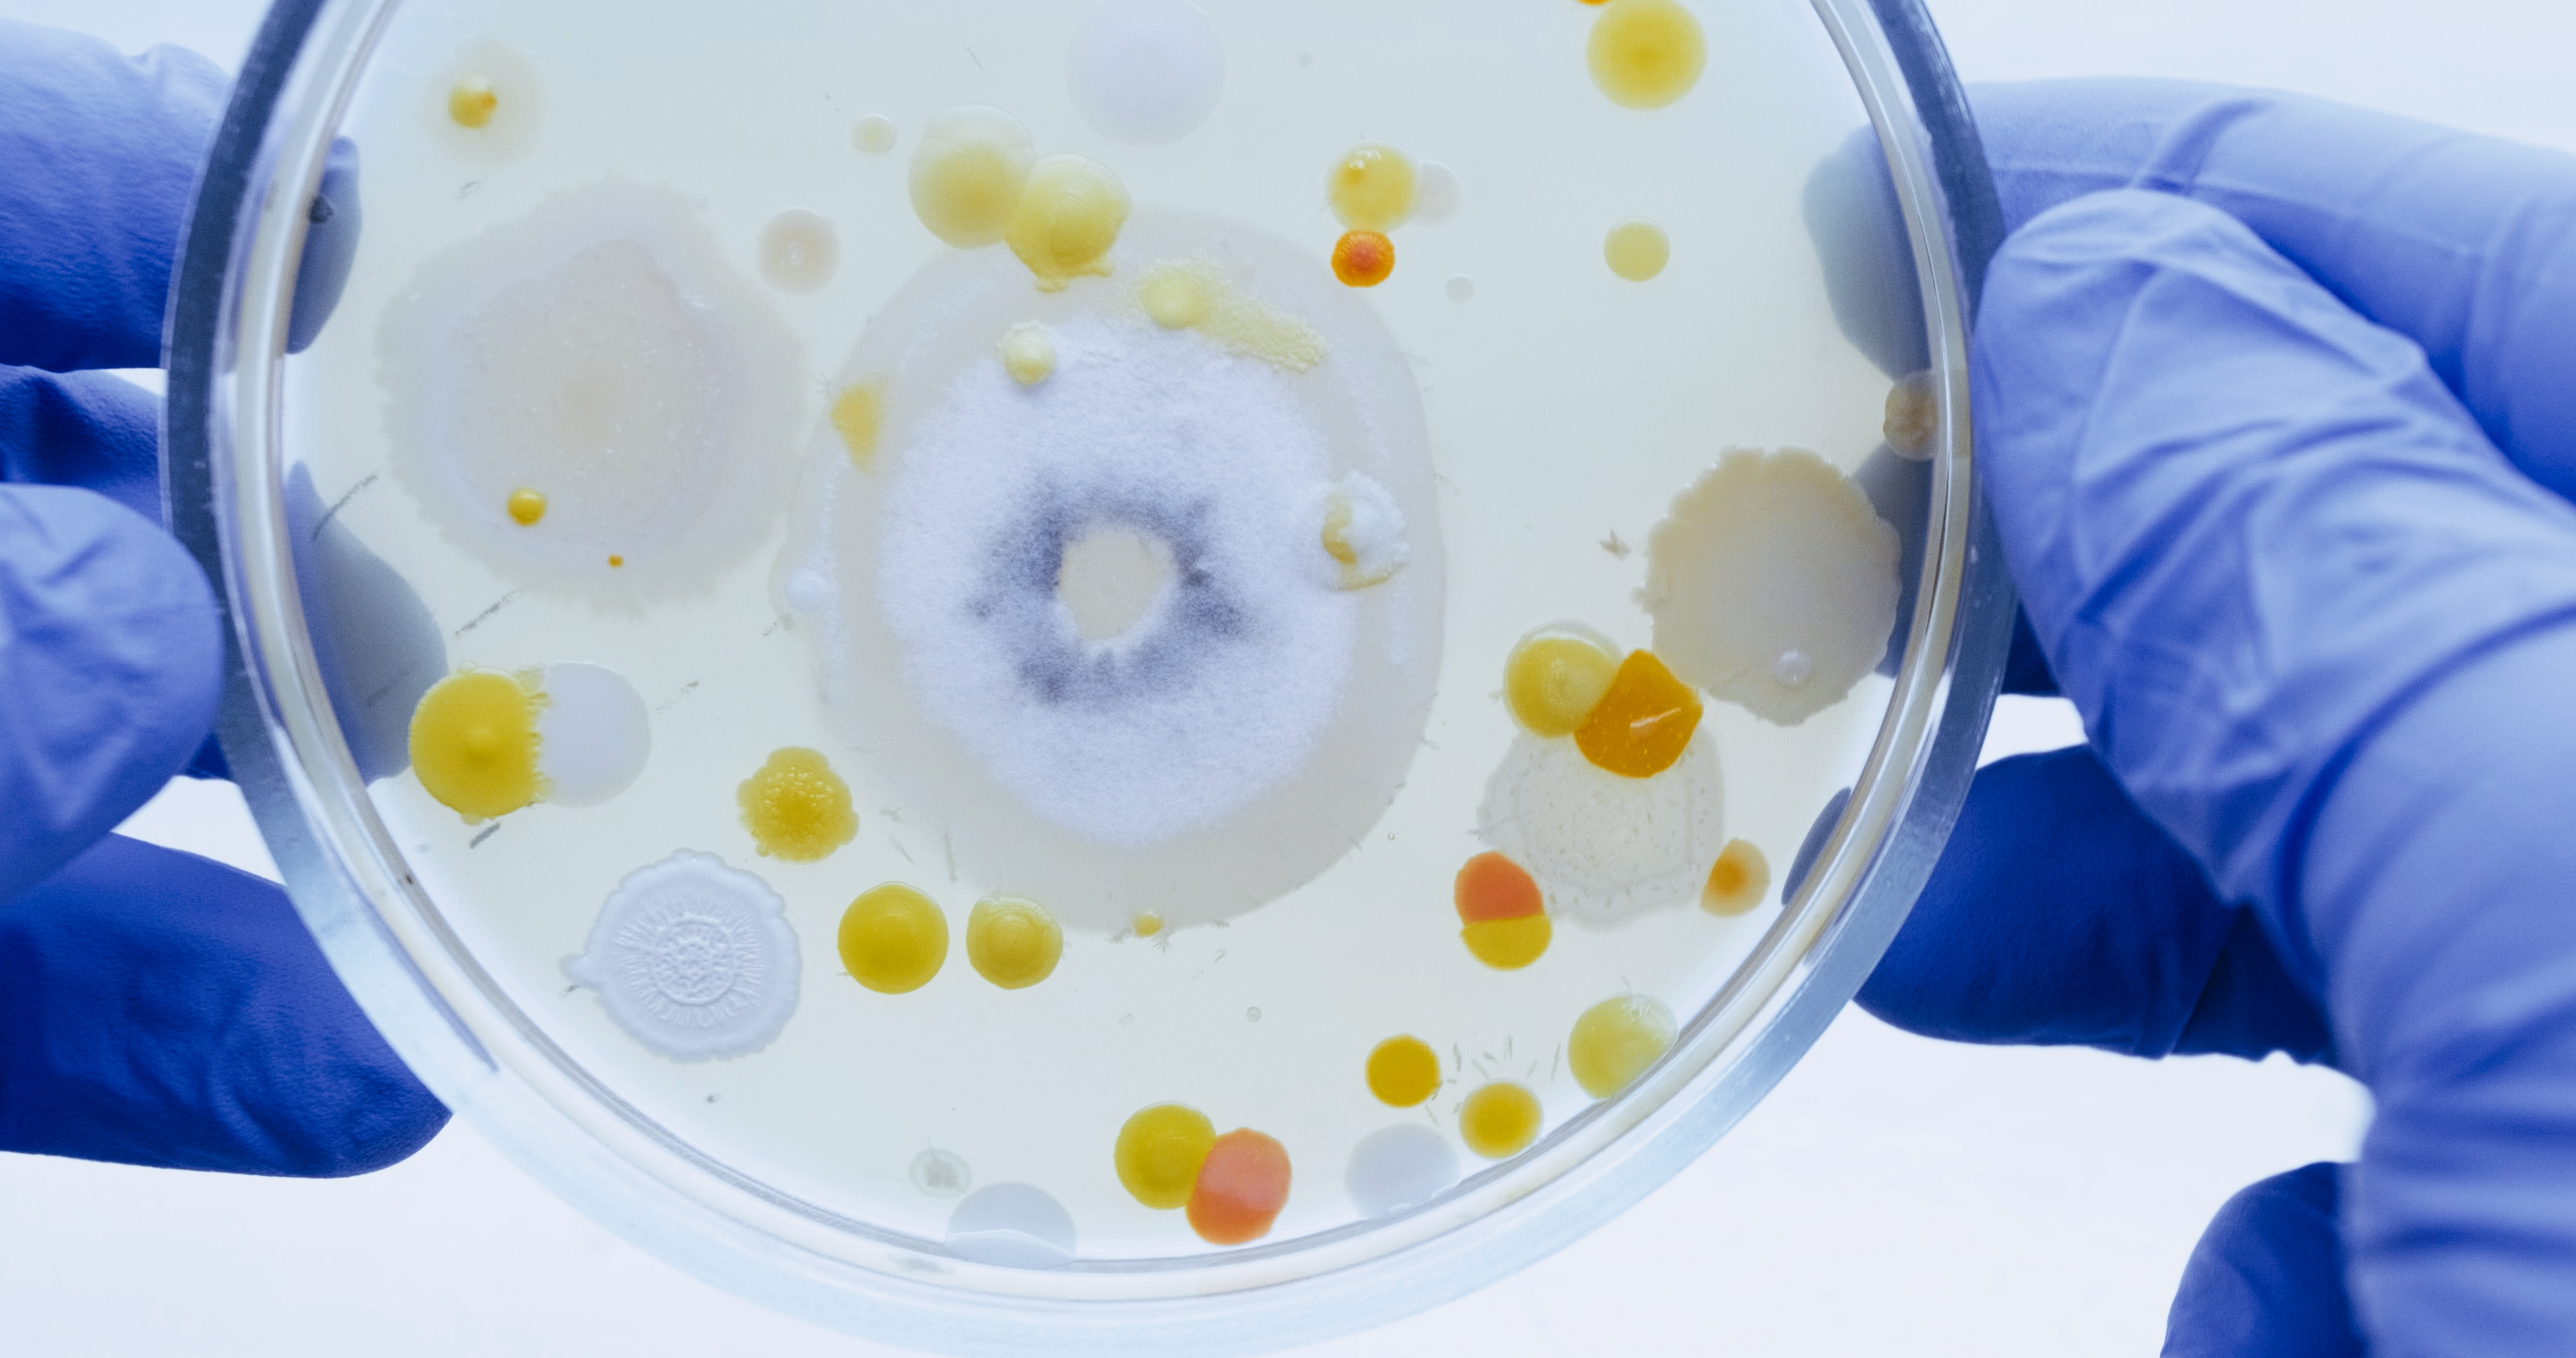
Top view of dining table

Safety, quality, authenticity and nutrition are key drivers in the modern food industry. Consumers want assurance that products are genuine, nutritional, high quality and safe. Claims relating to ingredients, composition and country of origin need to be evaluated to build customer trust.
Expert food testing solutions help operators in national and international food supply chains ensure their products meet market expectations, thereby reducing risk, improving efficiency and building consumer confidence.
Deliver marketable food products
Our solutions ensure the quality, safety and integrity of your food products.
Utilizing a global network of food testing laboratories, we provide analysis services for a wide range of parameters, including the identification of contaminants, food borne pathogens, spoilage organisms and allergens. In addition, our experts use the latest analytical methods to evaluate and validate the nutritional value, composition, authenticity and integrity of products and ingredients.
Why choose food testing services from SGS?
We are globally recognized as the benchmark for quality and integrity in food testing. Wherever you operate in the world, our experts are ready to support you with solutions that improve efficiency, reduce risk and ensure the delivery of safe, high-quality products to discerning markets.
Looking for something specific?
Search within Food Testing
Cocoshe Building, Block B, 4th Floor,
Agostinho Neto Close, Airport Residential Area P.O. Box 732,
Accra, Ghana